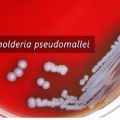
miniature

| <<< Octobre 2017 >>> | ||||||
| L | M | M | J | V | S | D |
| 1 | ||||||
| 2 | 3 | 4 | 5 | 6 | 7 | 8 |
| 9 | 10 | 11 | 12 | 13 | 14 | 15 |
| 16 | 17 | 18 | 19 | 20 | 21 | 22 |
| 23 | 24 | 25 | 26 | 27 | 28 | 29 |
| 30 | 31 | |||||
| Sélectionner tout le mois | ||||||
Lecture des variants génomiques: vers une médecine prédictive
Mardi 31 Octobre 2017 à 12:00 | Vie et Terre
Des fusions de gènes identiques de cancers humains et canins révélées
Mardi 31 Octobre 2017 à 00:00 | Vie et Terre
Découverte d'une potentielle cible thérapeutique pour lutter contre les trypanosomes
Mardi 31 Octobre 2017 à 00:00 | Vie et Terre
Tumeur du cerveau: la piste prometteuse des magnétosomes
Lundi 30 Octobre 2017 à 00:00 | Vie et Terre
La résistance aux médicaments, un problème de santé publique décrypté grâce à la levure !
Dimanche 29 Octobre 2017 à 12:00 | Vie et Terre
Physique des particules: la France entre dans la collaboration internationale BELLE-II
Samedi 28 Octobre 2017 à 00:00 | Physique
Diabète de type 1 et microbiote: les cellules MAIT comme biomarqueur et nouvelle cible thérapeutique
Vendredi 27 Octobre 2017 à 12:00 | Vie et Terre
La plus longue piste connue de dinosaure sauropode révélée dans le Massif du Jura
Vendredi 27 Octobre 2017 à 00:00 | Vie et Terre
La forme finale des organes dépend aussi du corset de protéines qui les entourent
Jeudi 26 Octobre 2017 à 12:00 | Vie et Terre
Découverte d'une protéine de synthèse "anti-gel" biodégradable
Jeudi 26 Octobre 2017 à 00:00 | Vie et Terre
Un gène identique impliqué dans la schizophrénie et trouble bipolaire
Mercredi 25 Octobre 2017 à 12:00 | Vie et Terre
Résistance aux antibiotiques: une nouvelle cible dans la paroi bactérienne
Mercredi 25 Octobre 2017 à 00:00 | Vie et Terre
Cartographie de la transition magnétique dans un alliage FeRh
Mardi 24 Octobre 2017 à 12:00 | Physique
Anémie de Fanconi: une connexion inattendue avec la machinerie d'épissage des ARNs
Mardi 24 Octobre 2017 à 00:00 | Vie et Terre
Un modèle animal inédit pour accélérer la lutte contre la maladie d'Alzheimer
Lundi 23 Octobre 2017 à 12:00 | Vie et Terre
Lutter contre l'acidité pour survivre: le bacille tuberculeux n'avait pas dit son dernier mot
Lundi 23 Octobre 2017 à 00:00 | Vie et Terre
UreG, une enzyme qui a besoin de désordre pour fonctionner
Lundi 23 Octobre 2017 à 00:00 | Vie et Terre
Les liens entre l'architecture 3D du génome et la construction du cerveau décodés
Dimanche 22 Octobre 2017 à 00:00 | Vie et Terre
Arrêt sur image: la transcription freine la mobilité d'un gène unique
Samedi 21 Octobre 2017 à 12:00 | Vie et Terre
Stockage minéral du CO2 dans les basaltes: les bactéries du sous-sol profond s'en mêlent
Samedi 21 Octobre 2017 à 00:00 | Vie et Terre
Le senseur énergétique AMPK régule le devenir des cellules souches musculaires adultes
Jeudi 19 Octobre 2017 à 12:00 | Vie et Terre
La variabilité des stocks biologiques de carbone dans l'océan Austral révélée par les flotteurs BGC-Argo
Jeudi 19 Octobre 2017 à 00:00 | Vie et Terre
Maladie d'Alzheimer: une modification de la protéine tau induisant les agrégats fibrillaires identifiée
Jeudi 19 Octobre 2017 à 00:00 | Vie et Terre
Des vaccins contre des agents pathogènes du bioterrorisme
Mercredi 18 Octobre 2017 à 12:00 | Vie et Terre
Record du monde pour la lecture de plastiques numériques
Mercredi 18 Octobre 2017 à 00:00 | Physique
Mise en orbite d'un satellite de surveillance de la qualité de l'air
Mardi 17 Octobre 2017 à 12:00 | Spatial
Une échographie linguale augmentée pour la rééducation orthophonique
Mardi 17 Octobre 2017 à 12:00 | Vie et Terre
Les télescopes de l'ESO détectent la toute première lumière issue d'une source d'ondes gravitationnelles
Mardi 17 Octobre 2017 à 00:00 | Astrophysique
Nouvelles avancées sur un virus méconnu: le virus de l'hépatite E
Mardi 17 Octobre 2017 à 00:00 | Vie et Terre
Un embryon aviaire pour retracer l'histoire d'un cancer métastatique dévastateur de l'enfant
Lundi 16 Octobre 2017 à 00:00 | Vie et Terre
Comment les cellules embryonnaires se déforment sans trop se forcer
Dimanche 15 Octobre 2017 à 12:00 | Vie et Terre
Détection d'un nouveau mécanisme dans la maladie d'Alzheimer
Dimanche 15 Octobre 2017 à 00:00 | Vie et Terre
Une vie foisonnante et insoupçonnée dans les caniveaux
Samedi 14 Octobre 2017 à 00:00 | Vie et Terre
Communication chez les plantes, un nouveau mécanisme basé sur une histoire d'eau
Vendredi 13 Octobre 2017 à 12:00 | Vie et Terre
Les P-bodies, terra incognita des cellules eucaryotes
Vendredi 13 Octobre 2017 à 12:00 | Vie et Terre
Un réseau cérébral capable d'anticiper les conséquences d'un impact
Vendredi 13 Octobre 2017 à 00:00 | Vie et Terre
Les anciens tsunamis en Méditerranée, mythe ou réalité ?
Vendredi 13 Octobre 2017 à 00:00 | Vie et Terre
Les multiples interactions d'une petite GTPase à la surface des membranes
Jeudi 12 Octobre 2017 à 12:00 | Vie et Terre
Une technique de pointe en reconnaissance faciale se généralise
Jeudi 12 Octobre 2017 à 12:00 | Numérique
Les anémones blanchissent, les poissons-clowns pâtissent
Jeudi 12 Octobre 2017 à 00:00 | Vie et Terre
Un motif de la paroi de lactobacilles, élément clé pour tamponner les effets de la sous-nutrition sur la croissan
Jeudi 12 Octobre 2017 à 00:00 | Vie et Terre
Un protocole pour uniformiser les méthodes de métagénomique
Mercredi 11 Octobre 2017 à 12:00 | Vie et Terre
Une interfaces homme-machine pour composer une mélodie par la pensée
Mercredi 11 Octobre 2017 à 12:00 | Vie et Terre
Quand un solide poreux garde ses propriétés à l'état liquide
Mercredi 11 Octobre 2017 à 00:00 | Physique
Un pompage du CO2 atmosphérique jusqu'à de grandes profondeurs océaniques
Mercredi 11 Octobre 2017 à 00:00 | Vie et Terre
Des poissons qui nagent côte à côte économisent de l'énergie
Mardi 10 Octobre 2017 à 12:00 | Vie et Terre
Les interactions protéines-acides nucléiques chez les plantes révélées par la microscopie confocale
Mardi 10 Octobre 2017 à 00:00 | Vie et Terre
Médicament anti-apeline: l'appel au secours des tumeurs du cerveau
Mardi 10 Octobre 2017 à 00:00 | Vie et Terre
L'impact des El Niño extrêmes sur le transport sédimentaire dans les Andes péruviennes occidentales
Lundi 9 Octobre 2017 à 00:00 | Vie et Terre
Comment Mycobacterium tuberculosis joue à cache-cache avec le système immunitaire
Lundi 9 Octobre 2017 à 00:00 | Vie et Terre
Le recrutement du protecteur Sgo2 par la kinase Mps1 assure la bonne qualité des ovocytes
Dimanche 8 Octobre 2017 à 12:00 | Vie et Terre
La capacité d'anticiper le moment où surviendra un son repose sur le système moteur du cerveau
Dimanche 8 Octobre 2017 à 00:00 | Vie et Terre
Les processus du manteau dans les failles de décrochement
Samedi 7 Octobre 2017 à 12:00 | Vie et Terre
Nouvelles méthodes de soudage pour l'industrie automobile
Vendredi 6 Octobre 2017 à 12:00 | Physique
Des règles européennes pour le contrôle des drones par géorepérage
Vendredi 6 Octobre 2017 à 12:00 | Aéronautique
MOSAIC sur l'ELT: un pas de géant vers l'univers profond
Vendredi 6 Octobre 2017 à 00:00 | Astronomie
Des ressorts fluorescents pour mesurer un gradient de force dans les protéines
Jeudi 5 Octobre 2017 à 00:00 | Vie et Terre
Médicaments hétérocycliques: une méthode de synthèse prometteuse
Mercredi 4 Octobre 2017 à 12:00 | Vie et Terre
Éruptions volcaniques, mousson africaine, El Niño: les processus physiques identifiés
Mercredi 4 Octobre 2017 à 00:10 | Vie et Terre
Un équilibre mitochondrial subtil indispensable à la vision
Mardi 3 Octobre 2017 à 00:00 | Vie et Terre
Un projet pour identifier la maladie d'Alzheimer à différents âges
Lundi 2 Octobre 2017 à 12:00 | Vie et Terre
Le Yin et Yang des irradiations à faibles doses sur l'hématopoïèse
Lundi 2 Octobre 2017 à 12:00 | Vie et Terre
Alain Brillet et Thibault Damour, physiciens, lauréats 2017 d'une double médaille d'or du CNRS
Lundi 2 Octobre 2017 à 00:00 | Astrophysique
Aucun dossier répondant aux critères sélectionnés